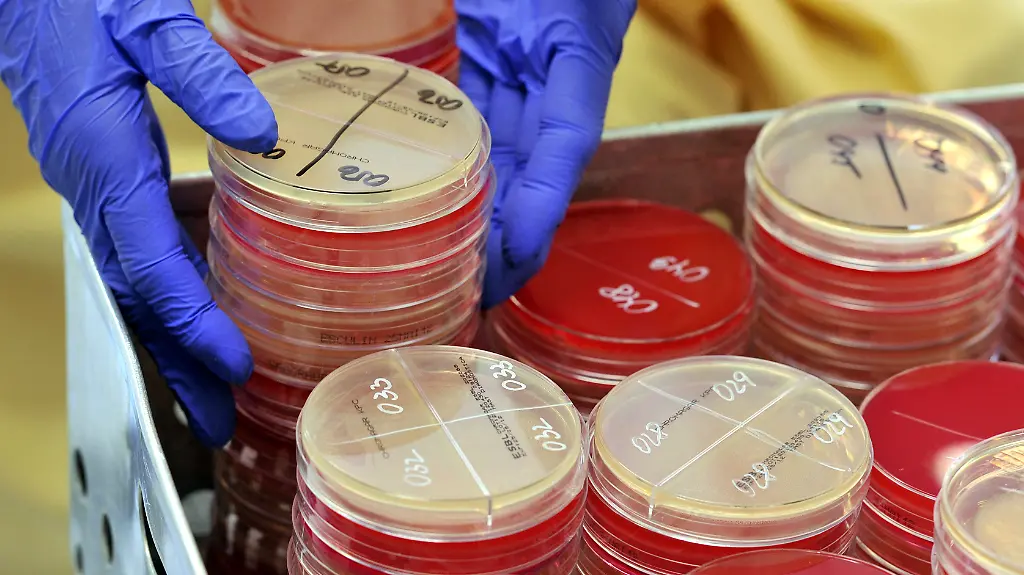
klinikkeime

Zehntausende Tote jedes Jahr Regierung sagt Keimen den Kampf an
Immer wieder sorgen sie für Schlagzeilen: Klinik-Keime. Antibiotika zeigen kaum noch Wirkung, 40.000 Patienten in deutschen Krankenhäusern sterben Jahr für Jahr an den gefährlichen Erregern. Nun spricht sich das Kabinett für strengere Gesetze aus.
Deutschland schluckt zu viel Antibiotikum. Ist die Grippe im Anmarsch, hoffen nach wie vor viele Patienten, dass ihr Arzt ihnen ein Antibiotikum verschreibt. Die Wirkstoffe gelten weithin als Allheilmittel. Und tatsächlich sind sie kleine Wunderwaffen – aber nur gegen Bakterien. Gegen eine Virus-Grippe kann kein Antibiotikum etwas ausrichten. Antibiotika töten Bakterien ab, gegen Viren sind sie wirkungslos. Überflüssige Verordnungen sind dennoch alles andere als selten.
Hinzu kommt: Deutschland schluckt Antibiotika oft auch falsch. Wenn es nach drei Tabletten wieder besser geht, ist die Verlockung groß, die Therapie abzubrechen und die restlichen vier Tabletten in der Packung zu lassen. So aber werden die krankmachenden Bakterien nicht komplett unschädlich gemacht. Vielmehr haben sie Gelegenheit, sich an das Antibiotikum zu gewöhnen. Das bedeutet: Die Bakterien werden gegen das Mittel resistent; sie werden widerstandsfähig. Eine solche Resistenz entwickeln sie auch bei übermäßigem, unkontrolliertem Einsatz der Antibiotika. Irgendwann hilft das Medikament dann nicht mehr. Es versagt nicht nur bei einem selbst, sondern auch bei allen anderen Patienten. Was dann?
Im Krankenhaus kann es jeden treffen
In diesem Fall muss ein anderes Antibiotikum her. Eines, das die Bakterien noch nicht kennen. Eines, dem sie nicht standhalten. Doch das Fatale ist: Viele gefährliche Bakterienstämme sind inzwischen multiresistent. Sie sind also so zäh, dass gleich mehrere Antibiotika nichts mehr gegen sie ausrichten können. In letzter Konsequenz kann das heißen, dass bakterielle Infektionen wieder – wie vor der Entdeckung des Antibiotikums – vermehrt zum Tod führen.
In Krankenhäusern stellen die multiresistenten Keime ein besonderes Problem dar. Das medizinische Personal trägt sie auf der Hand (die offenbar nicht in jedem Fall ausreichend desinfiziert ist) und gibt sie weiter. Immungeschwächte oder frisch operierte Menschen sind besonders ansteckungsgefährdet. Jedes Jahr infizieren sich rund 800.000 Klinik-Patienten mit den gefährlichen Krankenhaus-Keimen, so die Schätzungen der Deutschen Gesellschaft für Krankenhaushygiene. 40.000 von ihnen sterben sogar daran.
Damit es so nicht weitergeht, soll der Einsatz von Antibiotika in Deutschland neu geregelt werden – sowohl in der Medizin als auch in der Tierhaltung, denn da finden die Medikamente ebenfalls eine allzu großzügige Verwendung. Gesundheitsminister Hermann Gröhe stellte bereits im März einen Zehn-Punkte-Plan gegen die gefährlichen Keime vor.
Viele Infektionen wären vermeidbar
Etwa ein Drittel der Infektionen wäre durch geeignete Maßnahmen vermeidbar, heißt es in dem Entwurf des Ministers, dem das Kabinett nun zugestimmt hat. Der Gesetzentwurf sieht vor, dass Patienten vor geplanten Behandlungen auf multiresistente Erreger getestet werden, damit diese nicht ins Krankenhaus eingeschleppt werden. Außerdem sollen Kliniken schon den ersten Nachweis eines gefährlichen multiresistenten Erregers melden müssen. Über Hygienestandards sollen die Krankenhäuser künftig in allgemein verständlicher Sprache Auskunft geben müssen. Und Ärzte und Pflegepersonal – ob aus Kliniken oder Praxen – sollen regelmäßig zum Thema Resistenzen weitergebildet werden.
Die Ausbreitung multiresistenter Keime einzudämmen, ist eine Sache. Die andere ist die, multiresistente Keime doch irgendwann wirkungsvoll abtöten zu können. Und schließlich geht es auch noch darum, neue Resistenzen zu verhindern. Deswegen will die Regierung auch die entsprechende Forschung vorantreiben. Es sollen neue Antibiotika entwickelt, aber auch alternative Therapiemethoden gefunden werden. Auch Tests zur Schnelldiagnostik stehen auf dem Plan. Bisherige Bemühungen im Kampf gegen multiresistente Keime zeigten nicht die erhoffte Wirkung. Die "nationale Antibiotika-Resistenzstrategie", so die offizielle Bezeichnung des Gesetzentwurfes, soll es nun richten. Sie soll Tausenden Menschen das Leben retten.